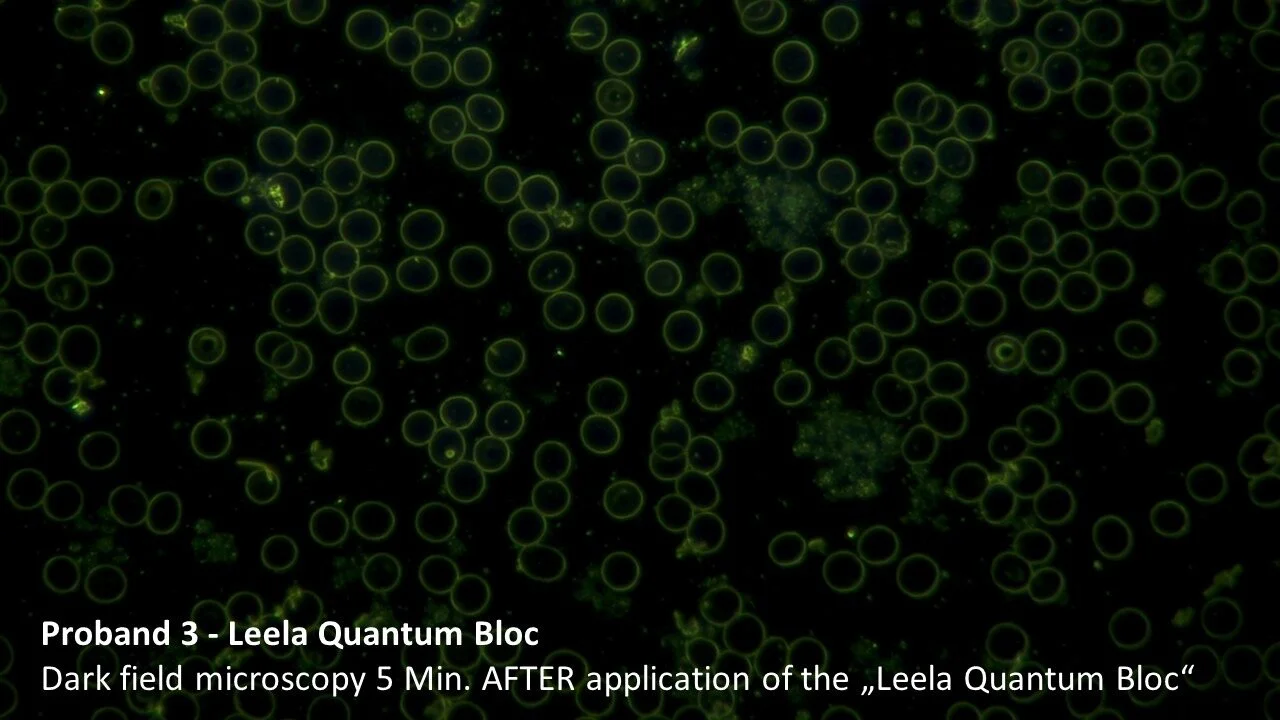

058. Quantum Energy & Healing Frequencies To Support Your Body & Energy Levels - Philipp Samor (LeelaQ)
This week, I'm blessed to have Philipp Samor von Holtzendorff-Fehling, the founder of Leela Quantum Tech (also known as LeelaQ) on the show. This is definitely one of my more "woo-woo" episodes and for many of you it will stretch your thinking, after all, what is quantum energy and quantum healing? But first let me back track. A good friend of mine, who's a hardcore biohacker and health nut said, "You have to meet this guy, he's doing some amazing things with EMF blocking and 5G." Many of you might already be familiar with the Somavedic device, which is a beautiful, handcrafted, precious stone that sits in your home and is designed to block out harmful EMF's such as 5G, harmonize your home with good frequencies, and even structure your water. Well, Philipp has informed me that LeelaQ's blocs can do what the Somavedic does but even more.
LeelaQ a variety of products ranging from capsules & frequency cards, to copper bracelets and fashion items to increase your energy level, activate your inner healing powers, become more stress resistant, powerful and able to let go and enjoy each moment. Philipp sent me one of his capsules that I wore around my neck for a week, that is designed specifically for men over their 40's to help with testosterone production, vitamins/minerals, and energy balance. I also was using this gold plated frequency card, which was titled Inner Peace and is designed to bring in frequencies that tune your vibration and energy field into those positive fields. The cool thing is it's just a card that you can slip in your back pocket. They also have water bottles that can structure your water, hats that can block EMF's and other clothing, and much more. I even went ahead and got an Infinity bloc to harmonize my entire home, which is something I'll be testing the next few months, and will update everyone with regards to overall energy and mood especially with my kids.
To learn more about Philipp and all the amazing things he and his team are doing, head over to LeelaQ to learn more. Philipp will also be speaking at Dave Asprey's Biohacking Conference in Orlando, Florida this year Sept 17-19th, so go and check him out. Philipp is one of the most generous people I have ever met and lives the abundance mindset. I am so grateful to have connected with such a beautiful human that is driven to go out and change the world in a powerful way.
Last but not least, I'm excited to tell you that I've just launched an 8 week program dedicated to busy and motivated men that want to lose weight and start living their higher purpose. We work on mindset, clarity work, diet/nutrition, exercise, sleep, habits, and much more. For more details, DM me @joelevancoaching or email info@joelevancoaching.com
Timeline
7:00 - How Phillip sees energy in people
9:02 - Why Phillip is bullish on the anti-aging molecule Carbon60
11:02 - The HEAL capsule and how it works
13:41 - How the healing frequency cards work
15:58 - The two institutes that actually test the capsule and EMF’s and the scientific studies that back up LeelaQ’s products
20:00 - How the gold Infinity bloc works
22:16 - Studies done with autistic children and changes in behavior & lyme disease
27:30 - Why the LeelaQ block does more than the Somavedic
34:00 - How the energy cards like Inner Peace work
42:35 - Can you use the capsule to get all your vitamins/minerals?
44:20 - How does the LeelaQ help with weight loss?
47:54 - How did Phillip come up with the name LeelaQ
51:20 - Exciting projects Phillip is working on
Other Resources/Links
Quantum Power Group (Telegram Group)
Books Recommended